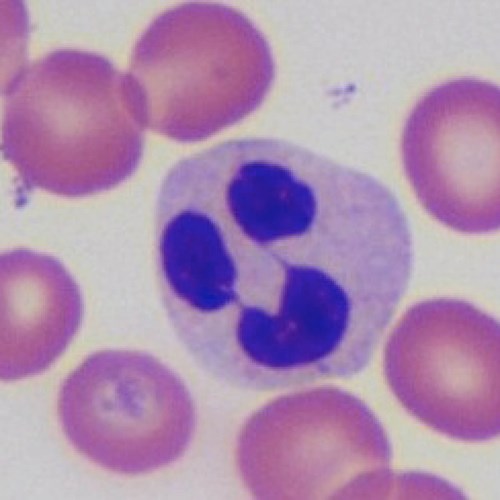

Key Information
CPD Hours: 42 hours
Course Length: Six weeks
Course Format: An intensive tutor-moderated online learning experience. Resources include online webinars and instruction videos for haematology and cytology, a multitude of case assessment exercises, supplementary reading material and discussion forums in which participants review and discuss cases with their colleagues and the tutors
Enrol Now
This course may run again in the future. To register your interest please contact us.
Alternatively you can download and email using our Registration Form
Course Information
- Microscopic skill development that leads to better diagnostic capability and efficiency
- Top tips on making high quality blood smears (that can be examined efficiently), how to improve the quality and diagnostic utility of fine needle aspirates, imprints and fluid preparations
- Top tips of optimising commonly used stains and how to change the microscope setup for haematology and cytology, and how to care for the microscope day to day to preserve diagnostic utility
- Systematic and efficient approach to the interpretation of peripheral blood smears including platelet estimation, regenerative vs. non-regenerative anaemia, key erythrocytes abnormalities, clinically important neutrophil changes (that the machines can’t see), other leukocyte abnormalities.
- Understanding the strengths and weaknesses of haematology analysers
- Systematic and efficient approach to common and/or characteristic skin masses (e.g. inflammation vs. neoplasia, round cells, epithelial cells, spindle cells tumours) and lymph node aspirates (reactive vs. neoplastic)
- Examples of common organ and cavity aspirates/lesions
- How to optimise your communication with pathologists/laboratories
Do you want to increase your skills in examining blood smears and fine needle aspirates to expand the clinical service you can provide to your patients? Are you in a practice where financial limitations don’t allow sending out bloods and cytologies to external labs? Would you like get more from your in-house analysers and avoid their errors?
The ever-widening availability of in-house haematology analysers have brought about a gap in knowledge of blood smear examination, which is essential for the reliable and safe use of these machines in the veterinary practice. The first three weeks of the course (haematology) helps practitioners to develop the necessary skills to prepare high quality blood smears, to perform optimal staining, to best setup the microscope for blood smear examination, and to carry out a systematic, highly efficient (3-5 min) blood smear examination in order to validate in-house analysis results and detect abnormalities that the machines can’t. Strengths and weaknesses of such analysers will be discussed.
The second half of the course focuses on common fine needle aspirate samples (skin lumps, lymph nodes, organs etc.) with the aim to provide a systematic approach to the assessment. Top tips will be shared to improve aspiration technique to provide more diagnostic samples, to achieve the best staining, and for microscopic skill development which will help with efficiency to utilise time on the microscope best.
The course is developed on a case-based teaching approach, with the addition of videos and other materials provided to achieve the above goals. An active tutor-moderated discussion forum is also used to discuss any questions regarding technique, the study cases, specific topics in haematology and cytology, and even cases participants see during the course in their practice.
Why do this course?
You will improve your skills and efficiency in preparing and assessing high quality blood smears and cytological samples.
Barbara Glanemann, DrMedVet DipECVIM PGDipVetEd FHEA MRCVS
Associate Professor in Small Animal Medicine
The Royal Veterinary College
Balazs Szladovits, DVM DipACVP PGDipVetEd MRCVS
Associate Professor in Clinical Pathology
The Royal Veterinary College
Relevant CPD courses you may find of interest
Getting the best out of your microscope – the essentials
Haematology and cytology online for veterinary nurses
Antimicrobial stewardship in small animal practice – why does it matter?
Acute kidney injury – recognising acute from chronic
The bleeding patient: Diagnosis and treatment
Webinar Plus: Master how to thrive (not just survive) in veterinary practice
Webinar Plus: A coaching approach to line management and leadership in the veterinary workplace